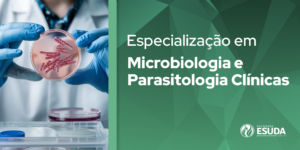

Especialização em Enfermagem em Urgências, Emergências e UTIs
Local: Recife | Área: Especialização - Saúde
Nome do Coordenador: Profª Adriana da Silva Dantas Email do Coordenador: drikadantas2007@hotmail.com Telefone do Coordenador: (81) 9.9575-7539 (para ligação de voz) e (81) 9.8753-0928 (para Whatsapp) Duração:10 meses, com aulas aos sábados, das 08h …